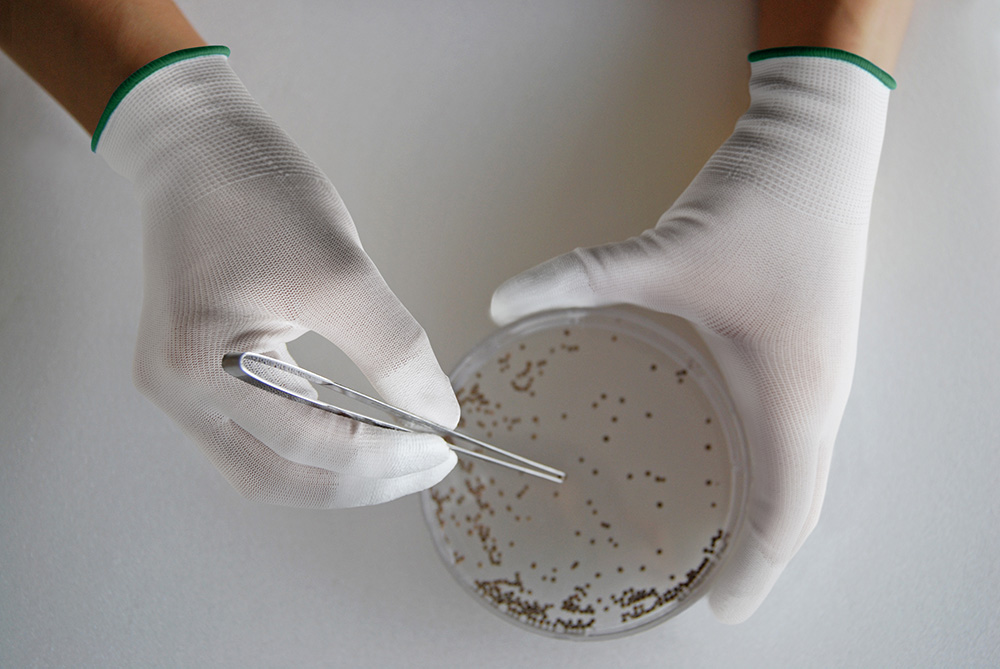
ユース画像（トップX手袋 10双入）

小さなものもしっかりキャッチ
指先に発泡ポリウレタンをコーティングしているため、スベリ止め効果を発揮します。

優れたフィット感
手によくフィットするため、指が動かしやすく細かな作業に適しています。
特 長
● 発泡ポリウレタン樹脂を指先にコーティングしているため、スベリ止め効果を発揮します。指サック特有のムレ・圧迫感から解放されます。
● 薄く、手によくフィットするため、指先感覚が必要な細かい作業に適しています。
● 縫い目のないシームレス編手袋のため、通気性に優れ、ムレにくく快適に作業ができます。
● 長繊維のウーリーナイロン糸を使用しています。
● 薄く、手によくフィットするため、指先感覚が必要な細かい作業に適しています。
● 縫い目のないシームレス編手袋のため、通気性に優れ、ムレにくく快適に作業ができます。
● 長繊維のウーリーナイロン糸を使用しています。
用 途
運輸・物流業 / 機械工業 / 自動車関連業 など
商品仕様
-
製品情報
発泡ポリウレタン製指先コート手袋
-
素材(樹脂部)
ポリウレタン
-
素材(繊維部)
ナイロン
ポリエステル その他 -
内容量
10双
-
生産地
中国
| サイズ | カラー | 製品寸法 | JANコード | |||
|---|---|---|---|---|---|---|
| 本体 | 裾 | 全長 | 手のひら まわり |
中指長さ | ||
| S | ホワイト | ホワイト | 19.0 cm | 17.0 cm | 6.5 cm | 4901792044875 |
| M | ホワイト | イエロー | 20.0 cm | 17.5 cm | 6.8 cm | 4901792044882 |
| L | ホワイト | ダークグリーン | 21.0 cm | 18.5 cm | 7.1 cm | 4901792044899 |
| XL | ホワイト | ライトブルー | 22.0 cm | 19.0 cm | 7.4 cm | 4901792044905 |
使用上の注意
● 体質によっては、かゆみ・かぶれ・発疹等をおこすことがあります。異常を感じたら使用を中止し、医師に相談してください。
● 樹脂部でも薬品や溶剤は透過するため、使用しないでください。
● 樹脂部でも水等の液体は浸透するため、触れないでください。
● 熱いものに触れないでください。火傷するおそれがあります。
● 刃物や鋭利なものを使用する作業には十分注意してください。
● 回転体を伴う作業(ボール盤・面取り盤等)には使用しないでください。手が巻き込まれるおそれがあります。
● 絶縁機能はないため、感電のおそれがある電気作業には使用しないでください。
● 繊維製のため、自己発塵があります。また、樹脂部においても摩耗すると発塵する場合があります。使用に際しては、発塵性を確認の上、使用してください。
● ナイロン糸を使用しているため、黄変する場合がありますが、品質には異常ありません。
● 保管する時には直射日光を避けてください。
● 手袋を廃棄する際は、各自治体の区分に従い適切に処分してください。
● 樹脂部でも薬品や溶剤は透過するため、使用しないでください。
● 樹脂部でも水等の液体は浸透するため、触れないでください。
● 熱いものに触れないでください。火傷するおそれがあります。
● 刃物や鋭利なものを使用する作業には十分注意してください。
● 回転体を伴う作業(ボール盤・面取り盤等)には使用しないでください。手が巻き込まれるおそれがあります。
● 絶縁機能はないため、感電のおそれがある電気作業には使用しないでください。
● 繊維製のため、自己発塵があります。また、樹脂部においても摩耗すると発塵する場合があります。使用に際しては、発塵性を確認の上、使用してください。
● ナイロン糸を使用しているため、黄変する場合がありますが、品質には異常ありません。
● 保管する時には直射日光を避けてください。
● 手袋を廃棄する際は、各自治体の区分に従い適切に処分してください。









